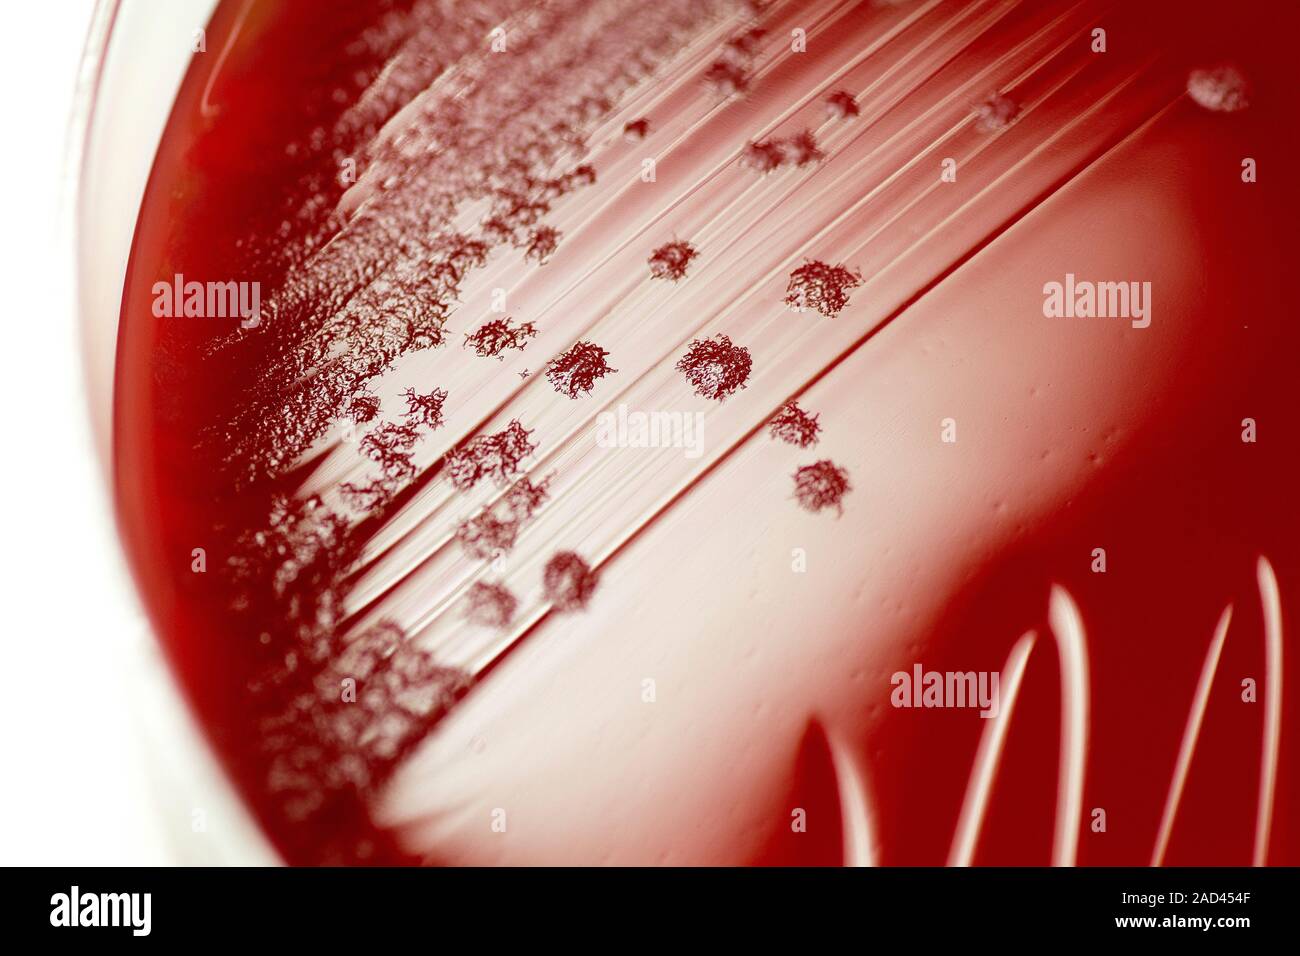

Агаре библия
Агаре библия 132 фото
Доброе утро хорошего дня мужчине прозе
Рождественская улица 45
Худею а на весах вес стоит
Улица бойчука северодвинск
Отжимал одеяла
Сфр по районам москвы
Freestyle bike
Махорка в огороде
Как найти выездные
Secret красноармейская ул 3 микрорайон заречный